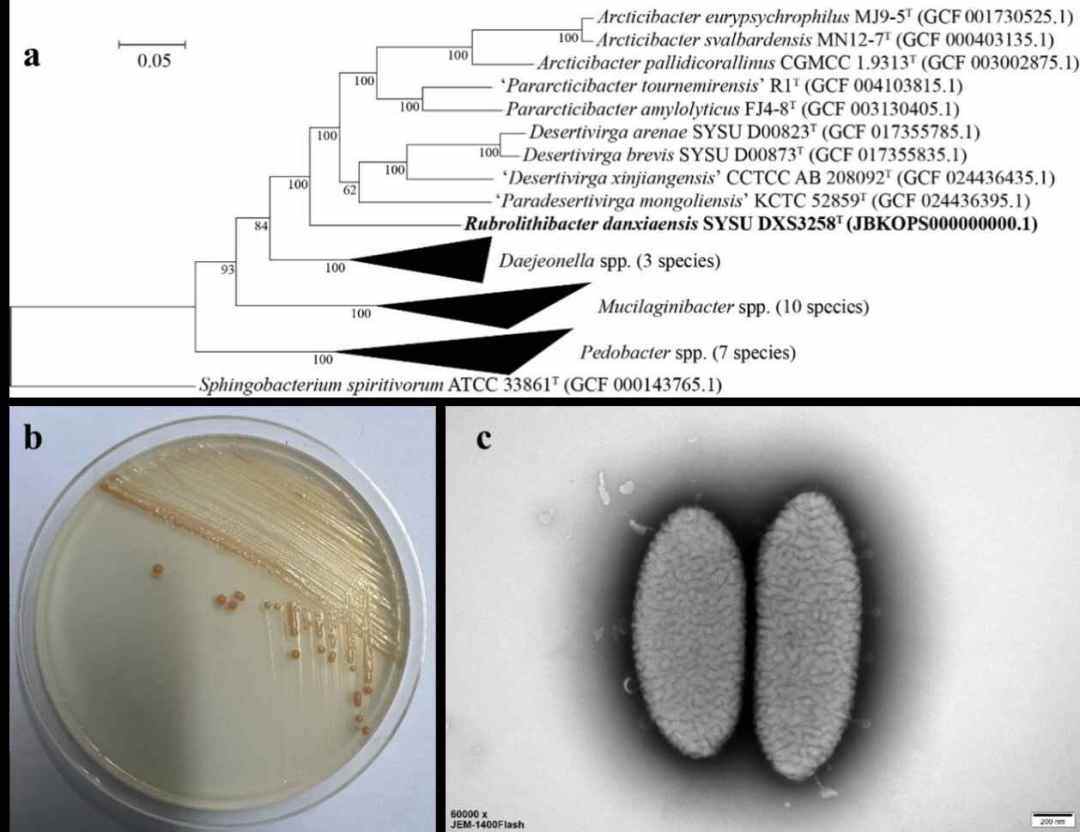

岩石不语藏春秋,菌落无声诉传奇。记者今天从世界自然遗产地广东丹霞山管委会了解到,在丹霞山看似沉默了千万年的赤红的岩层中,科学家们发现了一位“隐世居民”——丹霞红岩杆菌。
它不仅是微生物界的全新物种,更是首次被定义的“家族”(新属),如同人类发现了一个从未记载的少数民族部落。

这块看似普通的红色砾岩,经中山大学生命科学学院李文均教授团队实验室培养后,学者们发现竟藏着一类特殊的细菌(革兰氏阴性菌),它们如同岩石中的“隐形矿工”,在显微镜下现出真容:细胞呈短杆状,表面覆盖独特膜脂,仿佛穿着定制“防护服”。
这项重大发现近日正式发表于国际专业微生物学期刊 Antonie van Leeuwenhoek,这是丹霞山的第52个新物种,也是该团队继2023年在丹霞山发现丹霞黄色杆菌以来的第2个微生物新属新种。
“岩壁隐士”的独白:我在这块石头上修炼亿万年
故事从一块看似普通的红色砾岩开始。中大微生物科研团队在丹霞山的典型红层砂砾岩中采集了一块岩石样品,回实验室进行培养和分离。经过连续多轮纯化和生理特征筛查,成功获得了一株此前未见的革兰氏阴性细菌“SYSU DXS3258T”。
丹霞红岩杆菌的系统发育关系及形态特征(a.丹霞红岩杆菌及近缘物种系统发育树;b.丹霞红岩杆菌菌落形态;c.丹霞红岩杆菌细胞透射电镜图)。
为了确认这位“新居民”的独特性,科学家们动用了多重“基因刑侦技术”,这多重验证的精度,或堪比用北京的天文望远镜看清纽约街头的一枚硬币!
基因“身份证”对比:它的16S rRNA基因序列与近亲差异超过1.35%,约相当于人类和黑猩猩的基因差异级别。
“家族族谱”分析:全基因组相似度(ANI<95%)远低于“同种”标准,好比发现猫科动物中既有家猫又有狮子。
“化学特征”检测:它拥有专属的膜脂成分、脂肪酸组合和呼吸酶Q-7,就像给细胞装上了“定制防护服”和“高效能量转换器”。

这些数据综合证明:这种菌株不仅是一个新种,还代表着一个前所未有的新属。团队因此将其命名为丹霞红岩杆菌(Rubrolithibacter danxiaensis),意为“来自丹霞红岩的细菌”。
这个新发现使丹霞山的特有物种拼图增至52块。但这些已知物种也许仅占预估总量的万分之一,犹如一个人徜徉于藏书百万的图书馆里,只阅读了100本书。
人类看山是景,微生物看山是家
“丹霞红岩杆菌并非‘偶然路过’,它很可能是丹霞地貌长期演化过程中与环境共同适应、共同演进的‘原住民’。”相关学者告诉记者。

据介绍,丹霞地貌是由红色砂砾岩层在特定气候条件下风化剥蚀形成的奇特地貌类型,以其干旱、强烈的日照、酸性土壤和贫瘠基质闻名。这些条件对多数生物来说并不友好,却为某些微生物提供了独特的生存空间和“进化温室”。
“我们在菌株SYSU DXS3258T的基因组中发现了与铁氧化和还原有关的基因,这可能是对红色砂砾岩中铁含量丰富的响应。”研究人员指出,这类微生物的生理和基因特征,可能正是对丹霞环境长期适应的结果。
因此,这项发现不仅丰富了微生物分类学的内容,更提示人们:地貌与微生物之间存在着比人们想象中更紧密的生态联系,这也从微观的角度验证了廖文波教授团队提出的在丹霞山存在着独特的“丹霞区系”。
为什么这类发现很重要?
在普通人印象中,微生物总是“看不见摸不着”。但科学家们越来越意识到,微生物是地球生态系统中不可或缺的基础力量,尤其在地质作用、营养循环、环境修复,甚至气候调节中扮演重要角色。

形象地说,人们或许可以想象在一块岩石上,微生物们正上演着“钢铁是怎样炼成的”微观版。它们或分解岩石获取能量,或通过化学反应制造“岩石面膜”,在贫瘠环境中构建起独特的生存网络。这些奇妙的“炼金术士”们所施展的“神奇岩土改造术”,或许正是丹霞地貌历经亿万年不崩塌的秘密武器。
理性地分析,在丹霞山这样的地质遗产地,研究其“微观生态”,有多重意义。学者们分析道:“首先是丰富中国本土微生物资源数据库:目前全球已知微生物不到实际存在种类的1%,我国的地质多样性意味着潜藏着大量未被发现的菌种。”
“同时揭示特殊地貌的生物适应机制:新菌种的特殊性可反映当地环境的生态特征与选择压力。”
“第三是为生物科技提供新资源:新微生物常伴随着新代谢产物和酶类,对生物医药、农业、环保等领域具有潜在应用价值。”
“此外还可以服务国家公园建设,为丹霞山国家公园的生物多样性保护与科研科普提供基础支撑。”
一方岩土养一方菌
在丹霞山,人类看到的是奇峰怪石,而微生物看到的却是“五星级家园”。它们用数十亿年的进化智慧,把岩石变成土壤,让贫瘠之地绽放生命。这些微小的生命在这里扎根、繁衍,形成了一个看似平凡却又极其复杂的微观世界。

丹霞山的红色岩层如同天然的“时间胶囊”,保存着微生物与环境协同演化的珍贵纪录。这些微小生命用数十亿年的坚持告诉人们:即便在看似荒芜的岩石中,生命总能找到属于自己的生存之道。目前,李文均教授团队还在持续推进丹霞山微生物多样性的研究。
“这里的岩石、土壤和空气,承载着无数微小生命的繁忙与努力。这些微生物不仅在土壤中促进着养分的循环,还帮助人们了解这个世界是如何在细小的角落里默默运转的。丹霞红岩杆菌的发现,正是反映了丹霞山的特殊地貌对微生物多样性的独特影响。”
李文均教授表示,在人类社会,人们常说“一方水土养一方人”,在微观世界也有同样的规律。
“丹霞红岩杆菌和丹霞黄色杆菌,都在漫长的亿万年的地质环境变化中适应了这方水土,进化出了强大的生存能力,在人们看到不到的世界里为丹霞地貌、丹霞区系的发育和演化默默贡献自己的力量。”
它们不仅是这片大自然画卷中的一员,还是丹霞山生态多样性的一部分。通过这些微小的生命,人们得以窥见这个“红岩世界”的奥秘,也让人们明白,大自然中的每一个渺小的细节,都有它存在的意义和价值。
下次当你站在丹霞山,不妨低头看看脚下的“沉默之石”——那里可能正进行着比科幻电影更精彩的“炼金术士大战”。而人们要做的,就是保护好这些“奇妙土著”,因为它们的古老生存智慧,或许藏着人类打开未来的“神奇钥匙”。
文/广州日报新花城记者:卜瑜 通讯员:丹宣
图/丹霞山管委会、相关科研团队
广州日报新花城编辑:霍泽凯